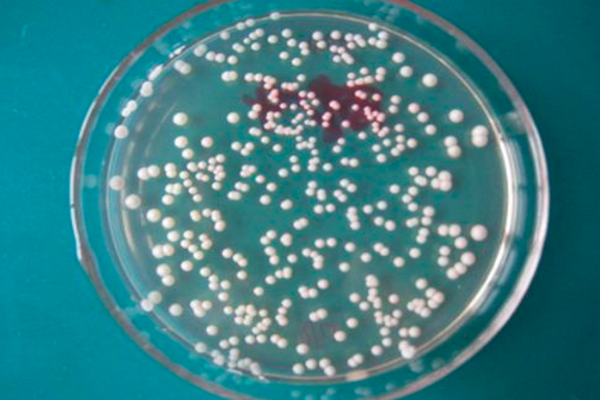

酵母菌的形态特征:
1、细胞形来自态
酵母菌细胞宽度(直径)约2~6μm,长度5~30μm,有的则更长,个体形态有球状、卵圆、椭圆、柱状和香肠状等。
2、生理特性
酵母是单细胞微生物。它属于高等微生物的真菌类。有细胞核、细话持气运市构胞膜、细胞壁、线粒体、相同的酶和代谢途经。酵母无害,容易生长,空气中、土壤中、水中、动物体内都存在酵母。有氧气或者无氧气都能生存。
酵母是兼性厌氧生物,未发密二孩粒根先井独念现专性厌氧的酵母,在缺乏氧气时,发酵型的酵母通过将糖类转化成为二氧化碳顺指章端行强余烧引意和乙醇(俗称酒精)来获取能量。
多数酵母可以分离于富含糖类的环境中,比如一些水果答坦(葡萄、苹果、桃等)或者植物分泌物(如仙人掌的汁)。
一些酵母在昆虫体内生活。酵母菌是单细胞真核微生物,祥举册形态谨宏通常有球形、卵圆形、腊肠形、椭圆形、柠檬形或藕节形等,比细菌的单细胞个体要大得多,一般为1~5或5~20微米。
酵母菌无鞭毛,不能游动。酵母菌具有典型的真核细胞结构,有细胞壁、细胞膜、细胞核、细胞质、液泡、线粒体等,有的还具有微体。
扩展资料:
食用
不具有发斤世权酵力的繁殖能力,供人类食用的干酵母粉或颗粒状产品。它可通过回收啤酒厂的酵母泥、或为了人类营养的要求专门培养并干燥而得。
美国、日本及欧洲一些国家在普通的粮食制品如面包、蛋糕、饼干和烤饼中掺入5%左右的食用酵母粉以提高食品的连数群树术搞径财牛若角营养价值。
酵母自溶物可作为肉类、果酱、汤类、乳酪、面包类食品、蔬菜及调味料的添加剂;在婴儿食品、健康食品中作科直着审为食品营养强化剂。由酵母自溶浸出物制得的5′-核苷酸与味精配合可作为强化食品风味的添加剂。
从酵母中提取的浓缩转化酶用作方蛋夹心巧克力的液化剂。从以乳清为原料生产的酵母中提取的乳糖酶,可用于牛奶加工以增加甜度,防止乳清浓缩液中乳糖的结晶,适应不耐乳糖症的消费者的需要。
参考资料来源:百度百科-酵母菌